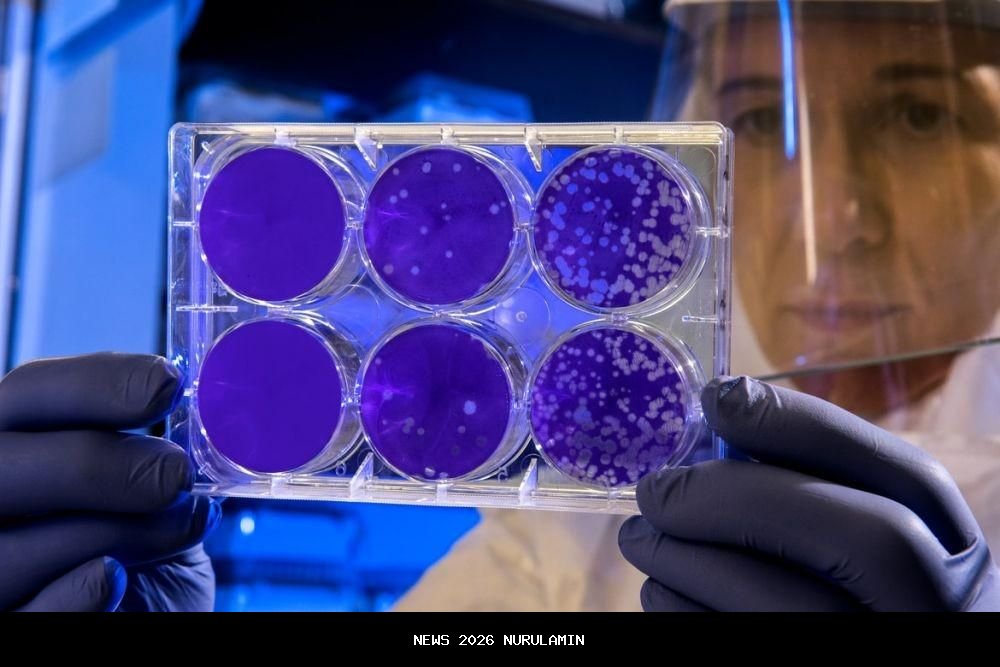

6 Hal Mengerikan yang Tersimpan dalam DNA Kita
Setiap individu memiliki DNA yang unik dan membentuk berbagai karakteristik fisik, mental, serta risiko kesehatan. Namun, di balik keunikan tersebut, ternyata DNA kita menyimpan banyak rahasia yang bisa mengejutkan. Berikut adalah enam hal mengerikan yang tersembunyi di dalam DNA kita:
1. Penyakit Kuno yang Diteruskan dari Nenek Moyang
Para ilmuwan genetika telah menemukan bahwa DNA kita menyimpan "dosa" masa lalu. Penyakit-penyakit yang pernah menyerang nenek moyang kita dapat dengan mudah diturunkan kepada keturunan mereka. Bahkan, sekitar 40% dari DNA manusia terbentuk oleh virus-virus kuno yang pernah menginfeksi leluhur kita. Ini membuat DNA kita menjadi campuran antara gen manusia dan jejak-jejak dari organisme lain.
TRADING OTOMATIS 24 JAM TANPA RIBET
Aiotrade adalah alat bantu trading autopilot nonstop di market SPOT Binance & Bitget
(Next: OKX, Tokocrypto & Saham)
CARA KERJA (Real)
- Harga Turun 1% → BELI OTOMATIS
- Harga Naik 1.2% → JUAL OTOMATIS
- Profit 1 siklus = 1.2%
- Mengulang selama market bergerak
KEUNGGULAN UTAMA
- Anti Loss & SPOT Market (Aman)
- LEGAL & Terdaftar BAPPEBTI
- Tanpa emosi, pantau chart otomatis
- Tidur/Sibuk, transaksi tetap jalan
2. Sel Mati yang Bisa Bangkit Kembali
Bagian dari DNA yang pernah berfungsi tetapi mati karena alasan tertentu bisa kembali hidup. Sayangnya, kebangkitan ini sering kali membawa efek samping yang tidak menyenangkan. Contohnya adalah penyakit otot yang disebut muscular dystrophy atau FSHD, yang disebabkan oleh aktivasi ulang bagian DNA yang seharusnya tidak aktif.
3. DNA yang Tidak Sepenuhnya Manusia
Ternyata, manusia juga memiliki DNA yang berasal dari spesies lain, seperti Neanderthal. Gen-gen ini ditemukan dalam populasi modern di Eropa dan Asia, dengan jumlah sekitar 1-4 persen dari total gen. Namun, gen ini tidak ditemukan pada masyarakat di daerah Afrika sub-Sahara. Ini menunjukkan bahwa DNA kita bukanlah sesuatu yang sepenuhnya murni.
4. Bom Waktu Kematian yang Diturunkan dari Kakek/Nenek
Penelitian menunjukkan bahwa perilaku kakek dan nenek dapat memengaruhi DNA cucu-cucunya. Di Swedia, penelitian menemukan bahwa penyakit dan ketergantungan bisa diturunkan melalui DNA dari kakek/nenek ke cucu, bahkan lebih kuat daripada dari orang tua ke anak. Oleh karena itu, hidup sehat dan teratur oleh kakek/nenek sangat penting untuk masa depan cucu-cucu mereka.

5. Kotoran Serangga yang Menyebabkan Penyakit
Di Amerika Selatan, ada jenis serangga yang dikenal sebagai "pembunuh" yang mendarat di wajah orang yang sedang tidur dan menghisap darah sambil pup. Parasit yang hidup di pup tersebut, yaitu T. cruzi, dapat masuk ke aliran darah dan merusak hati serta saluran pencernaan. Para peneliti menemukan bahwa parasit ini bisa diturunkan kepada keturunan dan terbaca melalui DNA.
6. Sisa Saudara Kembar yang Terbunuh saat Masih Janin
Ada kasus unik di mana seorang ibu bernama Lydia Fairchild dituduh menculik anaknya. Saat pemeriksaan DNA dilakukan, ternyata anak-anaknya tidak memiliki DNA yang sama dengan dirinya. Setelah investigasi lebih lanjut, diketahui bahwa Lydia pernah "membunuh" saudara kembarnya saat masih dalam kandungan dan menyerap bagian tubuhnya. Hal ini menyebabkan DNA rahim dan pembuluh darahnya berbeda dari biasanya.

DNA yang terdiri dari bagian-bagian kecil ini ternyata menyimpan informasi yang luar biasa. Dari beberapa contoh di atas, terlihat bahwa tes DNA harus dilakukan secara menyeluruh untuk mendapatkan informasi yang akurat. Jika hanya diperiksa pada bagian tertentu, bisa saja terjadi kesalahan persepsi.
FAQ Seputar Hal Mengerikan di Dalam DNA
Bisakah gen-gen kuno atau organisme asing tersembunyi di dalam DNA manusia?
Ya, ada bukti bahwa DNA manusia mengandung fragmen-fragmen yang berasal dari virus atau mikroorganisme lain yang telah berintegrasi ke dalam genom kita, menjadikan “arsip genetik alien” secara harfiah.
Bisakah mutasi DNA memicu perubahan ekstrem atau abnormal dalam tubuh tanpa kita ketahui sampai terlambat?
Ya — mutasi spontan atau yang diwariskan bisa memicu penyakit langka, kanker, atau kelainan perkembangan yang sering muncul tanpa peringatan sebelumnya.
Apakah bagian dari DNA kita yang disebut “junk DNA” bisa menyimpan rahasia yang menakutkan?
Ya — bagian non-pengkode gen ini bisa mempengaruhi ekspresi gen, mutasi, atau penyakit dengan cara yang belum sepenuhnya dipahami, sehingga potensi “waktu bom genetik” bisa tersembunyi di sana.